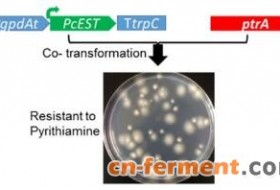

中国科学院青岛生物能源与过程研究所研究员吕雪峰带领的微生物代谢工程研究组长期从事丝状真菌天然产物生物合成研究,尤其是在土曲霉工业生产衣康酸和他汀类药物方面做了大量应用导向的代谢工程研究工作(Microb Cell Fact. 2014a, 2014b;metab Eng. 2017; Biotechnol J. 2018;ACS Synth Biol. 2019)。与此同时,该研究组还围绕丝状真菌天然产物基因组挖掘和生物合成机制展开了系统的探索性研究,于近期在土曲霉中发现了一种复杂、新颖的丝状真菌次级代谢产物合成及调控机制,发表在《德国应用化学》期刊上(Angew Chem Int Ed Engl, 2020,DOI: 10.1002/anie.201915514)。
丝状真菌次级代谢产物合成过程中一般是由核心酶(聚酮合酶PKS、非核糖体多肽合成酶NRPS和萜烯环化酶TCs等)负责合成化合物骨架,然后由其他辅助酶进一步修饰,这些酶的编码基因通常都集中位于同一个基因簇内。该研究组基于化合物结构分析、转录组分析和体内基因敲除验证,发现由位于两个独立基因簇中的四个核心基因(1个还原型PKS、2个非还原型PKS和1个NRPS-like)共同参与负责合成一类含有6/6/6/6的稠环骨架(6/6/6/6 tetracyclic system)的新化合物azasperpyranones,这有利于增加化合物的结构复杂性和生物活性。在此基础上,进一步通过体内基因敲除和体外酶学验证,对两个基因簇进行了功能分析,系统解析了该类化合物的生物合成途径。同时,研究人员还发现这两个独立的基因簇之间虽然存在空间距离,但是存在一种由三个转录调控因子介导的多层级转录调控,这使得它们能够相互协调共同参与化合物的合成。
这是首次在丝状真菌中解析两个独立基因簇、四个核心基因共同合成一个次级代谢产物,也是首次发现两个独立基因簇在多层级的协同调控机制下共同作用。该发现对于研究丝状真菌合成复杂化合物的生物机制具有重要意义,为真菌次级代谢产物生物合成途径解析和新型天然产物基因组挖掘提供了新思路。
该研究获得国家自然科学基金、山东省自然科学基金等的支持。
文章链接

图1. 两个独立基因簇通过多层级转录调控协同合成目标天然产物

图2. 提出的生物合成途径